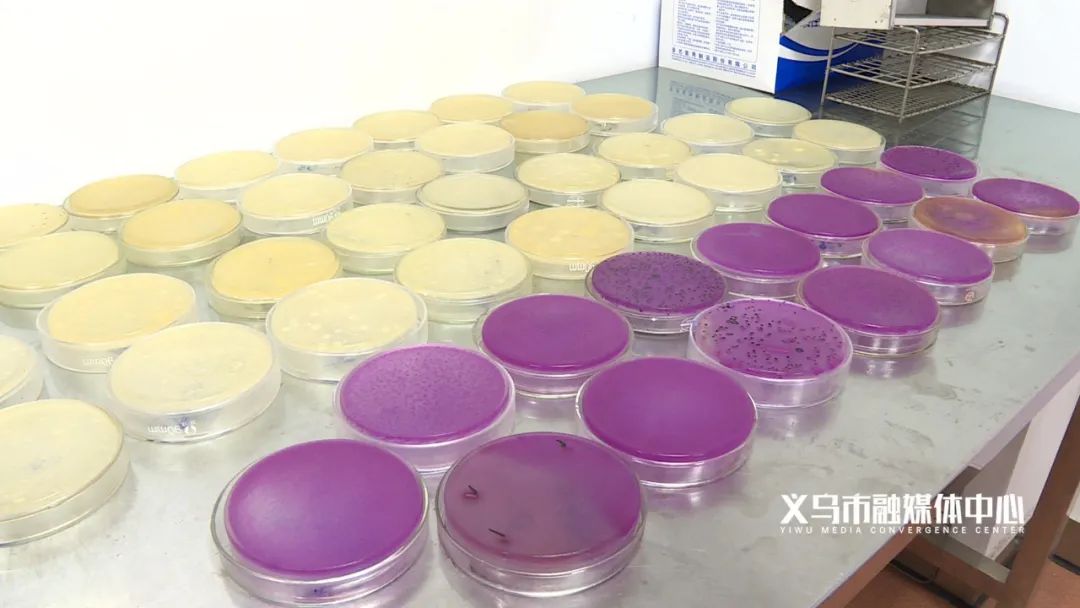
熟食细菌,熟食细菌滋生的条件是什么

猪耳朵、酱牛肉、猪脚蹄...是不少市民爱吃的熟食,但是大家是否关心过这些熟食微生物是否超标?是否可以放心食用?

带着这些疑虑,有市民将自己购买的刚出锅的5份五香牛肉和5份红烧猪手送到义乌市市场监管局产品(商品)质量检验研究院进行检测。
检测项目:菌落总数和大肠菌群
检验员首先对1份五香牛肉和1份红烧猪手进行取样,该样品为空白样品,与存放的样品做比对。

随后,检验员将剩余的4份五香牛肉和4份红烧猪手,模拟超市人员流动性大的环境,把它们放在电梯口附近,并将一份加盖,另一份暴露在空气中,来比较两者间的菌落总数和大肠菌群的生长速度和数量,分别放置4小时、8小时、24小时以及冰箱冷藏8小时后这4个时间点进行相应的取样检测。
从数据变化来看,随着时间的推移,菌落总数和大肠菌群数量都有大幅增加,最多的甚至达到了“多不可计”的程度。那这是否意味着这些熟食不合格呢?检验员的答案是:未必。

真相:目前没有标准可依据
因为散装熟肉制品不考核微生物指标,所以不适用预包装食品的GB 2726-2016《食品安全国家标准熟肉制品》中微生物限量进行判定。其次两者在生产环境、加工工艺、保质期和储存条件等方面存在差距,预包装食品是在有资质的加工场所生产加工,对生产车间、环境等都有杀菌消毒要求,并且定量包装在包装容器中,包装后产品不直接接触空气;而散装熟肉食品在售卖过程中直接暴露在空气中,空气中本身就存在很多的微生物,别说超市、熟食店这样复杂的环境,就是在自己家里做这些熟食,也很难避免被微生物污染。

散装熟肉食品的质量检测目前没有标准可依据,检验员出具的只是一份提供数据的检测报告。
虽然这个检测无法当作熟食产品是否合格的依据,但数据变化却为市民提了个醒。
温 馨 提 示
肉制熟食并非不能吃,而是吃熟食时应学会规避健康隐患。
一、预包装食品是优选。如果想吃,优先选择冷藏、有托盘且有保鲜膜密封的产品。
二、变色发黏的别买。如果熟食与其原本颜色不同,比如看上去发绿或过于红艳,就要警惕该产品已变质或可能过量使用了添加剂。如果熟食看着发黏则说明其已开始腐败,即使经过加热处理,仍有可能造成食物中毒。
三、煮沸后再热5分钟。
四、降价产品要当心。
来源 | 义乌市融媒体中心《消费现场》
作者| 吴逸男
编辑| 楼杭娟 金龙责编丨季媚瑶
编审 | 楼志锋